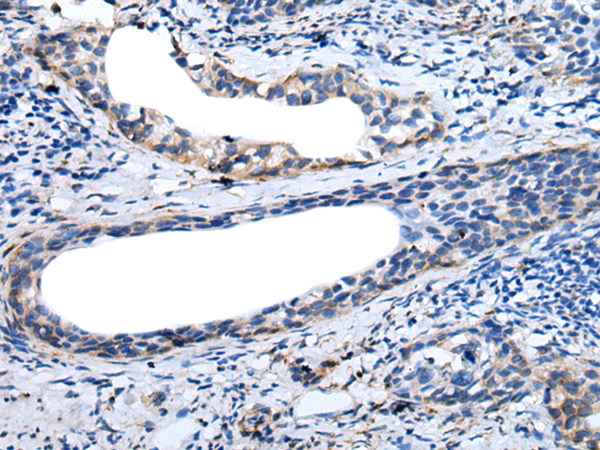

-
分类: 科研抗体货号: P12751别名: OMI; MGCA8; PARK13; PRSS25应用: WB,IHC反应种属: Human, Mouse
-
分类: 科研抗体货号: P12741别名: MTLRP应用: IHC反应种属: Human, Mouse, Rat
-
分类: 科研抗体货号: P12729别名: MDGI; FABP11; H-FABP; M-FABP; O-FABP应用: WB,IHC反应种属: Human, Mouse, Rat
-
分类: 科研抗体货号: P12750别名: CBP1; CBP2; OI10; gp46; AsTP3; HSP47; PIG14; PPROM; RA-A47; SERPINH2应用: WB,IHC反应种属: Human, Mouse
-
分类: 科研抗体货号: P12740别名: SCYB5; ENA-78应用: IHC反应种属: Human
-
分类: 科研抗体货号: P12728别名:应用: IHC反应种属: Human
-
分类: 科研抗体货号: P12749别名: EL52; HSPN; LAP2; HSP86; HSPC1; HSPCA; Hsp89; Hsp90; LAP-2; HSP89A; HSP90A; HSP90N; Hsp103; HSPCAL1; HSPCAL4; HEL-S-65p应用: IHC反应种属: Human, Mouse, Rat
-
分类: 科研抗体货号: P12727别名: VHR应用: WB,IHC反应种属: Human, Mouse
-
分类: 科研抗体货号: P12768别名: MK3; HGK5; HLK3; PCN3; HPCN3; KV1.3; HUKIII应用: IHC反应种属: Human, Mouse, Rat
-
分类: 科研抗体货号: P12767别名: JAKL; LJAK; JAK-3; L-JAK; JAK3_HUMAN应用: IHC反应种属: Human, Mouse, Rat

鄂公网安备42018502007531号
鄂公网安备42018502007531号

